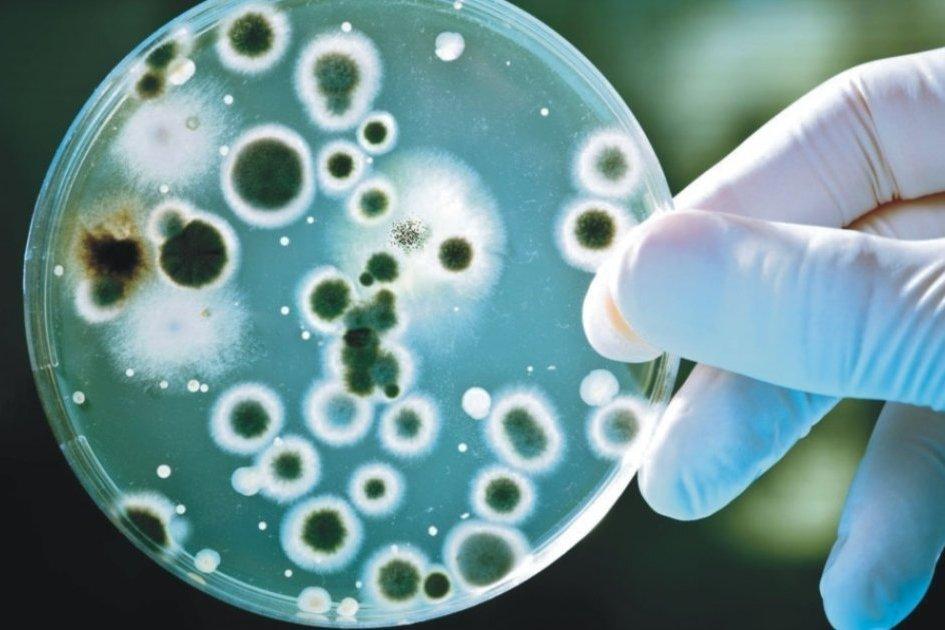
Лікарка розповіла, які інфекційні захворювання активізуються після затоплення територій

Лікарка розповіла, які інфекційні захворювання активізуються після затоплення територій
Повністю розмову з Юлією Левчук слухайте в доданому аудіофайлі
Фото ілюстративнеНегода 30 вересня призвела до затоплення вулиць та будинків в Одесі. Після затоплення територій там активізуються різні інфекційні захворювання. Лікарка-інфекціоністка Юлія Левчук розповіла в етері Громадського радіо про найпоширеніші з них.
За її словами, найчастіше на затоплених територіях зустрічаються кишкова паличка, гепатит A, норовірус, дизентерія та черевний тиф. Також можуть бути різні паразитарні інфекції, але вони проявлять себе пізніше — через довгий час після вживання неочищеної води чи продуктів, забруднених цими паразитами.
Жителям затоплених територій, найперше, варто утримуватися від вживання не бутельованої води. Тобто не вживати воду з колодязів чи інших місць, де вона може бути забруднена. Крім того, потрібно обов’язково знезаражувати продукти перед вживанням. Наприклад, обробити їх окропом. Що ж до води, то її обов’язково потрібно прокип’ятити, адже це — найкращий спосіб її знезараження. Якщо воду прокип’ятити неможливо (наприклад, відсутній газ чи електрика), то можна скористатися спеціальними таблетками для знезараження води. Однак цей процес досить тривалий: спершу потрібно дочекатися, поки не осяде осад, а потім профільтрувати воду через фільтр або тканину. До того ж ці таблетки допомагають лише проти бактерій та не є ефективними проти паразитів.
Говорячи про миття фруктів та овочів, інфекціоністка радила спершу промити їх бутельованою водою, а потім — облити окропом.
«Окріп — найкращий метод знезаражування від різних збудників», — наголосила Юлія Левчук.
Якщо уникнути інфікування не вдалося, то за перших симптомів потрібно вживати сорбенти. Зазвичай першими симптомами є нудота, біль у животі, блювання, діарея, підвищення температури. Якщо симптоми не зникають упродовж кількох днів, потрібно звертатися до лікаря.
Що має бути в домашній аптечці на випадок затоплення
Також Юлія Левчук розповіла, що потрібно мати в домашній аптечці на випадок затоплення. За її словами, там обов’язково мають бути:
- сорбенти (активоване вугілля або інші);
- електроліти (речовини, які можна розбавляти з водою і вживати при діареї або блювоті, оскільки саме тоді організм втрачає велику кількість електролітів — магнію, калію, натрію);
- протизапальні засоби;
- жарознижувальні та знеболювальні препарати.
Інфекціоністка розповіла, що від кишкових інфекцій немає вакцин. Але можна вакцинуватися від гепатиту A. Це можна зробити в будь-якому віці. Вакцина від гепатиту A вводиться двома дозами.
Громадське радіо потребує вашої допомоги для подальшого існування, і підтримати нас ви можете:
- за посиланням на монобанку https://send.monobank.ua/jar/3xdiYaF8Fu, де за найбільші донати на вас чекають чудові бонуси і подарунки від друзів та партнерів Громадського радіо
- ставши нашими патронами на Patreon
- PayPal: [email protected]
- Base by Mono
При передруку матеріалів з сайту hromadske.radio обов’язково розміщувати гіперпосилання на матеріал та вказувати повну назву ЗМІ — «Громадське радіо». Посилання та назва мають бути розміщені не нижче другого абзацу тексту
Топ 5 за 24 години
- Подкасти
- Розмови з ефіру